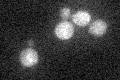
YDR499W
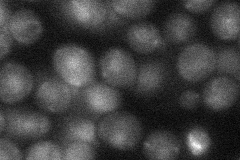
YDR499W
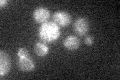
YDR499W

View description
Essential protein required for the DNA integrity checkpoint pathways; interacts physically with Mec1p; putative homolog of S. pombe Rad26 and human ATRIP
Localization:
Intensity:
Fold change:
Significance:
-
C’ GFP library in SD
below threshold19.32 -
N' NOP1pr-GFP in SD

punctate51.9063 -
N' TEF2pr-mCherry in SD

punctate,nucleus33.5099 -
N' NATIVEpr-GFP in SD
nucleus24.2419 -
N' TEF2pr-VC and Cyto-VN in SD

punctate39.2073 -
C’ GFP library in SD+DTT

cytosol17.840.92No -
C’ GFP library in SD+H2O2
cytosol18.50.95No -
C’ GFP library in Starvation Media

cytosol14.180.73No -
C’ GFP library on the background of Pup2-DaMP

below threshold -
C’ GFP library on the background of CCT mutant

below threshold19.1390.989922No
